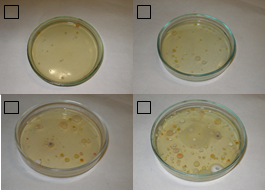

Министерство образования Республики Беларусь
Гомельская городская многопрофильная гимназия №14
ОТЧЕТ
О НАУЧНО-ИССЛЕДОВАТЕЛЬСКОЙ РАБОТЕ
Микробиологический анализ
школьных помещений
Исполнители
Губаревич Я.О.,
Пяткова С.П.
Руководитель темы
Свириденко Т.М.
Гомель 2006
РЕФЕРАТ
Отчет 20 с., 7 табл., 7 рис., 6 источников.
МИКРОБИОЛОГИЧЕСКИЙ АНАЛИЗ, МЕТОД КОХА, ЗАКРЫТЫЕ ПОМЕЩЕНИЯ
Цель работы – на основе микробиологических исследований определить степень загрязнения воздуха закрытых помещений и изучить динамику содержания микроорганизмов в воздухе в течение учебного дня.
Объектом исследования являются следующие школьные помещения: классный кабинет, коридор, столовая, спортзал.
Поставленные задачи решались в результате проведения лабораторных исследований. Для сравнительных оценок чистоты воздуха был использован седиментационный метод (метод оседания Коха). Было установлено, что наиболее загрязненным местом является спортзал. Наименьшую степень загрязнения имеет классная комната.
Установлено, что наблюдается тенденция увеличения количества микроорганизмов в воздухе коридора в течение учебного дня.
Проведенные исследования показывают, что в воздухе классного помещения содержание микроорганизмов увеличивается во время перемен и уменьшается во время уроков.
Выявлено, что на содержание микроорганизмов в воздухе одних и тех же помещений отличается в разные времена года.
СОДЕРЖАНИЕ
Введение
1 Аналитический обзор
1.1 Культивирование бактерий
1.2 Санитарно – бактериологическое исследование воздуха
2 Объекты и методы исследования
2.1 Объекты
2.2 Методы исследования
2.3 Методика расчета
3 Результаты и обсуждение
3.1 Сравнительный анализ школьных помещений в один период времени
3.2 Сравнительный анализ одного помещения в разные периоды времени
3.3 Сравнительный анализ одного помещения в разные периоды времени при наличии дополнительных факторов
3.4 Сравнительный анализ помещений в течение всего учебного дня
Заключение
Список использованных источников
ВВЕДЕНИЕ
Воздух является средой, содержащей значительное количество микроорганизмов. С воздухом они могут переноситься на значительные расстояния. В отличие от воды и почвы, где микробы могут жить и размножаться, в воздухе они только сохраняются некоторое время, а затем гибнут под влиянием ряда неблагоприятных факторов: высыхания, действия солнечной радиации, смены температуры, отсутствия питательных веществ и др. Наиболее устойчивые микроорганизмы могут долго сохраняться в воздухе и обнаруживаться там с большим постоянством. К такой постоянной микрофлоре воздуха относятся споры грибов и бактерий, сарцины и другие пигментообразующие кокки.
Количество микроорганизмов в воздухе колеблется в значительных пределах и зависит от метереологических условий, расстояния от поверхности земли, от близости населенных пунктов и т. д. Наибольшее количество микробов содержит воздух промышленных городов, наименьшее – воздух лесов, гор [1]. Много бактерий находится в воздухе помещений, где неизбежно массовое хождение людей (кинотеатры, театры, школы, вокзалы и т. д.), сопровождающееся поднятием в воздух пыли [2].
Цель настоящей работы – на основе исследований определить степень загрязнения воздуха закрытых школьных помещений. Для достижения поставленной цели необходимо было решить ряд задач:
1. определить количество микроорганизмов, содержащихся в воздухе различных помещений;
2. изучить динамику содержания микроорганизмов в воздухе в течение учебного дня.
1. АНАЛИТИЧЕСКИЙ ОБЗОР
1.1
Культивирование бактерий
Культивирование (выращивание) микробов, в частности бактерий, проводится на питательных средах. Посев бактерий на среды делают бактериальной петлей (иглой), шпателем, пастеровской или обычной градуированной пипеткой.
Выросшие на поверхности плотных сред изолированные макроскопические скопления биомасс, являющиеся продуктом размножения одной – единственной клетки. Называются колониями. Колонии представляют собой чистую культуру бактерий, которую, накопив на средах, используют для определения видовой принадлежности микроорганизма.
Методы и техника посева материалов и культур микробов.
Посев бактериальной петлей на скошенную и жидкую среды: 1) пробирку с чистой культурой бактерий и пробирку со стерильной незасеянной средой берут в левую руку и держат пальцами в наклонном положении так, чтобы их содержимое не проливалось; 2) в правую руку, как перо, берут петлю и в вертикальном положении стерилизуют в пламени горелки; 30 пробирки из пробирок вынимают одновременно, зажимают их между мизинцем и ладонью правой руки и тотчас же обжигают края открытых пробирок; 4)прокаленную петлю вводят в пробирку, охлаждают с незасеянной средой, ополаскивая петлю в бульоне или же зигзагообразными движениями распределяют по скошенной поверхности агара; 5) петлю извлекают, обжигают края пробирок и закрывают их проведенными через пламя пробками. Затем бактериальную петлю стерилизуют, пробирки надписывают и ставят в штатив.
Посев градуированной или пастеровской пипеткой
: пробирки держат под небольшим углом, градуированную или пастеровскую пипетку проводят через пламя и, сняв пробки, опускают в пробирку, затем насасывают определенное количество материала, переносят его в питательную среду и выдувают. Пробирки закрывают, а пипетки помещают в дезинфицирующий раствор.
Посев уколом
производят в полутвердые агаризованные среды и мясо – пептонный желатин, залитые в пробирки столбиком. Пробирки держат вверх дном, насквозь прокалывая среды иглой или петлей. Посев уколом в столбик применяют для выращивания анаэробных микробов, выявления протеолитических свойств, длительного хранения культур.
Посев в чашки Петри с плотной питательной средой осуществляют шпателем или бактериальной петлей. Плотные питательные среды (МПА, Эндо, Левина, Плоскирева) разливают в чашки следующим образом: флакон или пробирку с расплавленной средой берут в правую руку, левой рукой вынимают пробку, обжигают горлышко флакона, большим и указательным пальцами левой руки слегка приподнимают крышку чашки Петри и, не касаясь краев крышки, вводят под нее горлышко флакона или пробирку, наливая 15-20 мл среды. Быстро закрывают флакон и крышку. Чашку Петри слегка покачивают для равномерного распределения среды и оставляют до застывания. Затем переносят ее в термостат, переворачивая вверх дном, снимают крышку и подсушивают в таком положении 15-20 мин.
Посев шпателем
. Шпатели готовят из стеклянных палочек толщиной 4-5 мм, согнутых в виде треугольника, заворачивают в бумагу и стерилизуют в сухожаровом шкафу. Их можно также стерилизовать, смачивая спиртом с последующим его сжиганием. Пластинчатые среды засевают шпателем, круговым движением распределяя по всей поверхности внесенную в центр чашки Петри каплю материала или взвеси микробов. Во время посева крышку чашки Петри поддерживают левой рукой, чашка остается слегка приоткрытой. Далее тем же шпателем поочередно засевают вторую и третью чашки Петри, после чего шпатель погружают в банку с дезинфицирующим раствором. Чашки переворачивают, надписывают и ставят в термостат вверх дном, чтобы избежать размывания растущих колоний на среде капельками конденсационной воды, в большом количестве скапливающимися на внутренней поверхности крышки при обычном ее положении.
Посев бактериальной петлей
. Исследуемую жидкость набирают петлей и, не прикасаясь к стенке пробирки, удаляют излишнее ее количество. Чашку Петри с агаризованной средой помещают на столе вверх дном. Донную часть чашки держат левой рукой вертикально, петледержатель – большим и указательным пальцами правой руки и легкими движениями наносят параллельные штрихи по всему диаметру поверхности среды [3].
1.2 Санитарно-бактериологическое исследование воздуха
В атмосферном воздухе содержится большое количество микробов – почвенных, сапрофитов, попадающих в воздух вместе с мельчайшими частицами почвы. Среди них находятся спорообразующие палочки, пигментные бактерии, грибы и дрожжи.
В воздухе закрытых помещений обнаруживаются микроорганизмы, постоянно обитающие в больших количествах на слизистых оболочках верхних дыхательных путей человека. Они выделяются в окружающую среду при чиханье, смехе, кашле и разговоре с мельчайшими частицами слюны и носоглоточной слизи.
От больных с локализацией патологического процесса в полости рта и верхних дыхательных путях на ряду с условно патогенными микроорганизмами – стафилококками и зеленящими стрептококками – выделяются в окружающую среду патогенные микробы- гемолитические стрептококки группы А, бактерии дифтерии, коклюша, туберкулеза и др. в зависимости от этиологии заболевания. Микробиологический анализ воздуха на патогенную флору производит только по эпидемическим показаниям.
Для повседневной санитарно-гигиенической оценки воздуха определяют:
1. общее количество микробов, находящихся в 1 м3
воздуха;
2. количество в том же объеме воздуха санитарно-показательных микробов. По концентрации этих микробов определяют степень загрязнения воздушной среды аналогично тому, как по титру кишечной палочки оценивают качество питьевой воды.
Обнаружение в воздухе закрытых помещений данных микробов, обладающих признаками патогенности, является показателем эпидемического неблагополучия данного объекта.
Норматив по оценке бактериальной загрязненности воздуха в настоящее время нет. Критерием для оценки чистого и загрязненного воздуха в жилых, невентилируемых помещениях (табл. 1 и 2) приняты показатели, предложенные А. И. Шафиром [4].
2. ОБЪЕКТЫ И МЕТОДЫ ИССЛЕДОВАНИЯ
2.1 Объекты
Микробиологический анализ проходил в следующих помещениях гимназии: классная комната, коридор, столовая, спортзал (рис. 1). В классной комнате и коридоре материал для проведения исследований был получен в различные периоды учебного дня. Изучение содержания количества микроорганизмов в воздухе проводилось в 3-ной повторности.
2.2 Методы исследования
Для определения степени загрязнения воздуха в закрытых помещениях использовалось два вида питательных сред: ГРМ – агар и Агар – Эндо – ГРМ.
Таблица 1. Критерии для оценки загрязненности помещений по числу микроорганизмов в 1м3
воздуха
| Оценка воздуха |
Летний режим |
Зимний режим |
| Всего микроорганизмов |
Санитарно-показательных микробов |
Всего микроорганизмов |
Санитарно-показательных микроорганизмов |
| Чистый |
1500 |
16 |
4500 |
36 |
| Грязный |
2500 |
36 |
7000 |
124 |
Таблица 2. Санитарно-микробиологические нормативы воздуха в хирургических отделениях
| Помещение |
Условия работы |
Допустимые показатели |
| Микробное число в 1м3
|
Содержание |
| Патогенных стафилококков |
Патогенных
стрептококков
|
Операционные
Предоперационные и перевязочные
Палаты
|
При малых операциях
При операциях на центральной нервной системе
До начала операции
После
операции
До начала
работы
Летом
Зимой
|
Не выше 700
Не выше 15-70
Не выше 500
Не выше 1000
Не выше 750
Менее 3500
Менее 5000
|
Не должны
содержаться
в 250л
То же
Менее 24
Менее 52
|
Не должны
содержаться
в 250л
То же
Менее16
Менее 36
|
Питательный сухой агар для культивирования микроорганизмов (ГРМ - агар).
Состав панкреотический гидролизат рыбной муки…24,0
в граммах натрий хлористый…………………………. …..4,0
на 1л воды: агар микробиологический………………..12,0+
2,0
Способ приготовления среды:
38,0 г порошка размешать в 1 л дистиллированной воды, кипятить 1-2 минуты до полного расплавления агара, фильтровать через ватно-марлевый фильтр, разлить в стерильные флаконы и стерилизовать автоклавированием при t = 1210
С в течение 15 минут. Среду охладить до t = 45-500
C, разлить в стерильные чашки Петри слоем 4-5 мм. После застывания среды чашки подсушить при t = 37+
10
C в течение 40-60 минут.
 
  
Рисунок 1 – Школьные помещения, в которых проводился анализ. А – классная комната, Б – коридор, В – столовая, Г – спортзал
Питательная сухая среда для выделения энтеробактерий (Агар – Эндо - ГРМ).
Состав панкреотический гидролизат рыбной муки…...12,0
в граммах экстракт пекарных дрожжей……………………..1,0
на 1л воды: натрий хлористый………………………………...3,4
лактоза…………………………………………….10,0
сульфит натрия…………………………………….0,8
натрий фосфорнокислый 2 – замещенный………0,5
фуксин основной………………………………..…0,2
агар…………………………………………...10,0+
2,0
Способ приготовления среды:
36,7 г среды размешать в 1 л дистиллированной воды, кипять 2- 3 минуты до полного расплавления агара, профильтровать через ватно-марлевый фильтр, снова довести до кипения, охладить до t = 46-500
С и разлить в стерильные чашки Петри слоем 5-6мм. После застывания среды чашки подсушить при t= 37+
10
C в течение 40-60 минут.
Наиболее старым методом микробиологического анализа воздуха является седиментационный метод
(метод оседания Коха). Его используют только при исследовании воздуха закрытых помещений. Для этого чашки Петри с питательной средой при исследовании общей бактериальной загрязненности воздуха оставляют открытыми в местах отбора проб в течение 5-10 минут. По окончании экспозиции чашки закрывают и помещают в термостат при 370
С на 24 ч, а затем при комнатной температуре выдерживают еще сутки. О степени загрязненности воздуха судят по количеству выросших колоний. Данный метод пригоден для сравнительных оценок чистоты воздуха [6].
2.3 Методика расчета
Учет посева бактерий из воздуха производят путем подсчета выросших колоний бактерий отдельно. Зная площадь чашки Петри, можно определить количество микроорганизмов в 1м3
воздуха. Для этого: 1) определяется площадь питательной среды в чашке Петри по формуле πr
2
; 2) вычисляют количество колоний на площади 1 дм2
;
3) пересчитывают количество бактерий на 1м
3
воздуха [5].
Примерный расчет. В чашке Петри диаметром в 10 см
выросло 25 колоний.
1) определяют площадь питательной среды в чашке Петри по формуле 3,14*52
или 3,14*25 = 78,5 см2
2) вычисляют количество колоний на площади 1 дм
, равного 100 см2
25колоний – 78,5 см2
х=25*100/78,5=32 колоний
х колоний – 100 мм2
т. е. на площади 1 дм2
имеется 32 колонии.
3) пересчитывают количество бактерий на 1м3
воздуха, который равен 1000л.
Содержащиеся 32 колоний бактерий на площади 1 дм2
соответствуют объему 10л
воздуха. Чтобы узнать количество в 1м3
воздуха, составляют пропорцию:
32 – 10
х=32*1000/10=3200
х – 1000
Следовательно, в 1м3
воздуха содержится 3200 бактериальных телец.
3. РЕЗУЛЬТАТЫ И ОБСУЖДЕНИЕ
В ходе исследований для каждой микробиологической оценки использовалось по три чашки Петри. Колонии микроорганизмов, выросших на среде ГРМ-агар, представлены на рисунках 2-5. Необходимо отметить, что применение среды Эндо показало отсутствие кишечных палочек в изученных школьных помещениях.
На основании подсчета колоний, выросших в чашках Петри, была проведена оценка содержания микроорганизмов, которые содержатся в воздухе различных помещений в разные периоды учебного дня. Полученные результаты представлены в таблицах 3-5.
Рисунок 2 – Микробиологический анализ: А – классного кабинета, Б – школьного коридора, В – школьной столовой, Г – спортзала
3.1 Сравнительный анализ школьных помещений в один период времени
На первом этапе исследования было проведено сравнение данных, полученных в разных помещениях примерно в один период времени – от 4 до 5 перемены. Из таблицы 3 и рисунка 3 хорошо видно, что наименьшее количество микроорганизмов (1571) было выявлено в классном помещении, а наибольшее (16220) – в спортзале.
Таблица 3. Количество микроорганизмов, содержащееся в 1м3
воздуха школьных помещений
| Помещение |
1-ая чашка |
2-ая чашка |
3-я чашка |
Среднее |
| Класс |
1910 |
637 |
2165 |
1571 +
473 |
| Коридор |
3949 |
3439 |
1371 |
2920 +
788 |
| Столовая |
5222 |
2929 |
5605 |
4585+
836 |
| Спортзал |
23439 |
8407 |
16814 |
16220 +
4350 |
Однако необходимо отметить, что выявленные различия между классом и коридором, а также коридором и столовой не достоверны по t-критерию Стьюдента. Также следует добавить, что, исходя из литературных данных (таблица 1), эти помещения можно отнести к числу «чистых». Среди рассмотренных помещений только спортзал может рассматриваться в качестве «относительно грязного». По-видимому это объясняется тем, что занятие физкультурой, подвижные игры приводят к поднятию пыли, следовательно и микроорганизмов, находящихся в ней. Различия в сравниваемых парах помещений – класс-спортзал, коридор-спортзал и столовая-спортзал, являются достоверными с 1% или 5% уровнем значимости.
3.2 Сравнительный анализ одного помещения в разные периоды времени
На втором этапе исследований был проведен сравнительный анализ загрязненеия воздуха в одном и том же помещении, но в разные периоды учебного дня. Объектом для данного исследования был выбран коридор. На таблице 4 и на рисунке 4 представлены данные о содержании микроорганизмов в воздухе в течение учебного дня.
Таблица 4. Количество микроорганизмов, содержащееся в 1м3
воздуха школьного коридора в разные периоды времени
| Коридор: |
1-ая чашка |
2-ая чашка |
3-я чашка |
среднее |
| До 1 урока |
1146 |
1371 |
1371 |
1296 +
75 |
| 1 перемена |
1783 |
1529 |
2166 |
1826 +
185 |
| 5 перемена |
3949 |
3949 |
1371 |
2920 +
788 |
Из рисунка 4 видно, что содержание микроорганизмов в воздухе постепенно увеличивается в течение учебного дня. В то же время, наблюдаемые различия не являются достоверными по t-критерию Стьюдента. Кроме того, как следует из данных, приведенных в таблице 4 разброс значений может быть значительным. Так, на 5 перемене анализ двух чашек показал, что в 1 м3
воздуха содержится 3949 микроорганизмов, в то время как исходя из данных третьей чашки в воздухе находится 1371 микроорганизм. Таким образом, можно говорить только о тенденции к возрастанию численности микроорганизмов в течение учебного дня.
3.3 Сравнительный анализ одного помещения в разные периоды времени при наличии дополнительных факторов
На третьем этапе был также проведен анализ изменения содержания микроорганизмов в воздухе в одном помещении (класс химии), но при наличии двух дополнительных факторов: 1) проветриваемость помещения, 2) количество людей и интенсивность их передвижения. Полученные данные представлены в таблице 5 и рисунке 5.
В классе в течение всего дня были открыты форточки, что способствовало проветриванию помещения. Однако наблюдается резкое увеличение количества микроорганизмов во время 1 перемены, когда происходила смена различных классов. Таким образом, резкий скачок количества микроорганизмов, по-видимому, объясняется увеличением количества людей в помещении. При этом, проветриваемость помещения не оказывает существенного влияния на содержание микроорганизмов в воздухе в это время.
Однако на 5 перемене люди в классной комнате отсутствовали и это привело к снижению численности микроорганизмов в воздухе. Все это говорит о первостепенном влиянии именно такого фактора, как количество людей и интенсивность передвижения на степень загрязненеия воздуха микроорганизмами. Проветриваемость же помещений возможно оказывает свое влияние на общее количество микроорганизмов, но не на динамику их содержания.
Таблица 5. Количество микроорганизмов, содержащееся в 1м3
воздуха классного помещения в разные периоды времени
| Класс: |
1-ая чашка |
2-ая чашка |
3-я чашка |
Среднее |
| До урока |
509 |
637 |
254 |
467 +
113 |
| 1 урок |
127 |
382 |
509 |
339 +
112 |
| 1 перемена |
4713 |
2420 |
2930 |
3354 +
695 |
| 5 перемена |
1910 |
637 |
2165 |
1571 +
473 |
| 6 урок |
509 |
509 |
891 |
636 +
127 |
Следует добавить, что наблюдается некоторое уменьшение количества микроорганизмов на уроках по сравнению с переменами. Это также подчеркивает большую значимость интенсивности движения по сравнению с проветриваемостью помещений.
3.4 Сравнительный анализ школьных помещений в течение всего учебного дня
На четвертом этапе был проведен сравнительный анализ классного кабинета и коридора в течение всего учебного дня. Динамика содержания микроорганизмов в классном помещении представлена в таблице 6 и на рисунке 6, а коридора – в таблице 7 и на рисунке 7. Следует отметить, что данный анализ проводился в зимний период времени. По-видимому, это объясняет факт снижения микроорганизмов в соответствующие периоды учебного дня в одних тех же помещениях по сравнению с осенними исследованиями (см. таблицы 4 и 5). Выявлено, что тенденция снижения численности микроорганизмов во время уроков по сравнению с переменами, выявленное в осенний период (таблица 4), была подтверждена и в зимний период (таблица 6). По-видимому, динамика содержания микроорганизмов в воздухе связана с интенсивностью передвижения людей. Единственным исключением является 1 урок, что скорее всего объясняется наличием опоздавших учеников, в результате чего во время проведения эксперимента интенсивность передвижения людей была достаточно велика.
Что касается гипотезы о постепенном увеличении микроорганизмов к концу учебного дня, то в отношении классной комнаты сделать какие-либо окончательные выводы невозможно. Два пика увеличения – на 4 перемене и после уроков могут быть вызваны посторонними факторами, которые не учитывались первоначально при постановке экспериментов. Сами исследователи на 4 уроке находились в спортзале, где, как было показано ранее (таблица 3), наблюдается наибольшая загрязненность воздуха. Таким образом, непосредственно исследователи могли оказаться причиной наблюдаемого на 4 перемене резкого возрастания численности микроорганизмов. После же уроков, когда весь класс начал собираться домой, интенсивность движения резко возрасла по сравнению с обычными переменами. Вследствие этого, повышенная численность микроорганизмов после уроков может быть объяснена как увеличением загрязнения воздуха к концу учебного дня, так и интенсивностью движения. Относительно исследований в коридоре необходимо отметить, что здесь тенденция к увеличению количества микроорганизмов к концу учебного дня, при примерно одинаковой численности людей и интенсивности их передвижения, прослеживается более четко. От 1 перемены к 5 перемене численность микроорганизмов в воздухе постепенно увеличивается, аналогично тому как это наблюдалось и в осенний период (таблицы 4 и 7, рисунки 4 и 7).
Таблица 6. Количество микроорганизмов, содержащееся в 1м3
воздуха классного помещения
| класс |
1-ая чашка |
2-ая чашка |
3-я чашка |
Среднее |
| До урока |
127 |
127 |
254 |
170 +
42,5 |
| 1 урок |
382 |
254 |
764 |
467 +
153 |
| 1 перемена |
254 |
891 |
127 |
424 +
236,3 |
| 2 урок |
254 |
254 |
509 |
340+
84,9 |
| 2 перемена |
509 |
509 |
893 |
637+
127,8 |
| 3 урок |
254 |
382 |
382 |
340+
42,4 |
| 3 перемена |
127 |
382 |
893 |
467 +
225,1 |
| 4 урок |
254 |
127 |
127 |
170 +
42,5 |
| 4 перемена |
5350 |
3694 |
1273 |
3440+
1183,6 |
| 5 урок |
127 |
254 |
509 |
297+
112,4 |
| 5 перемена |
893 |
127 |
764 |
595+
236,1 |
| 6 урок |
254 |
891 |
127 |
424+
236,3 |
| После уроков |
891 |
1146 |
1401 |
1146+
147,2 |
Таблица 7. Количество микроорганизмов, содержащееся в 1м3
воздуха коридора
| коридор |
1-ая чашка |
2-ая чашка |
3-я чашка |
Среднее |
| До урока |
764 |
0 |
0 |
255+
254,7 |
| 1 перемена |
127 |
637 |
1019 |
722+
297,2 |
| 2 перемена |
893 |
893 |
382 |
723+
170,3 |
| 3 перемена |
509 |
637 |
1655 |
934+
362,7 |
| 4 перемена |
3694 |
1528 |
2038 |
2420+
653,7 |
| 5 перемена |
1146 |
1019 |
1146 |
1104+
42,5 |
| После уроков |
509 |
509 |
127 |
382+
127,3 |
Четвертую перемену можно не учитывать, поскольку здесь, по-видимому, пик численности объясняется теми же причинами, что и в классе на 4 перемене. Главным же фактором уменьшения загрязнения воздуха после окончания учебного дня (6 перемена) следует рассматривать уменьшение количества людей.
ЗАКЛЮЧЕНИЕ
1) Наибольшее количество микроорганизмов выявлено в воздухе спортзала, а наименьшее – классной комнаты.
2) Наблюдается тенденция увеличения количества микроорганизмов в воздухе коридора в течение учебного дня.
3) В воздухе классного помещения содержание микроорганизмов увеличивается во время перемен и уменьшается во время уроков.
4) Количество микроорганизмов в воздухе в первую очередь зависит от численности людей в помещении и интенсивности их передвижения.
5) Содержание микроорганизмов в воздухе одних и тех же помещений отличается в разные времена года.
СПИСОК ИСПОЛЬЗОВАННЫХ ИСТОЧНИКОВ
1 Федоров М.В. Микробиология. – М.: Гос. Изд-во сельхозлитературы,1960.– 350 с.
2 Бакулина Н.А., Краева Э.Л. Микробиология.– М.: Медицина, 1980.– 338 с.
3 Павлович С.А., Пяткин К.Д. Медицинская микробиология. – Минск: Высшая школа, 1993. – 200 с.
4 Лабинская А.С. Микробиология с техникой микробиологических методов исследования.– М.: Медицина, 1968.– 392 с.
5 Черемисинов Н.А., Боева Л.И., Семихатова О.А. Практикум по микробиологии.– М.: Высшая школа, 1967.– 168 с.
6 Шлегель Г.Х. Общая микробиология.– М.: Мир, 1987.– 566 с.
|